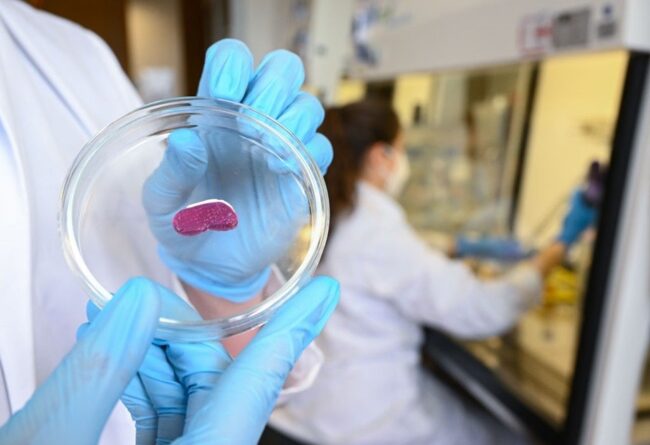

DF tem 500 novas vagas de emprego com salários de até R$ 2,2 mil
Nesta sexta-feira (6/10), as agências do trabalhador do Distrito Federal dispõem de 485 vagas de emprego, boas notícias para quem está procurando um novo emprego. Para quem ficar interessado, basta ir presencialmente a uma das 14 unidades ou realizar o cadastro do currículo no Sine Fácil. Benefícios são oferecidos em todos os cargos. Pessoas com…